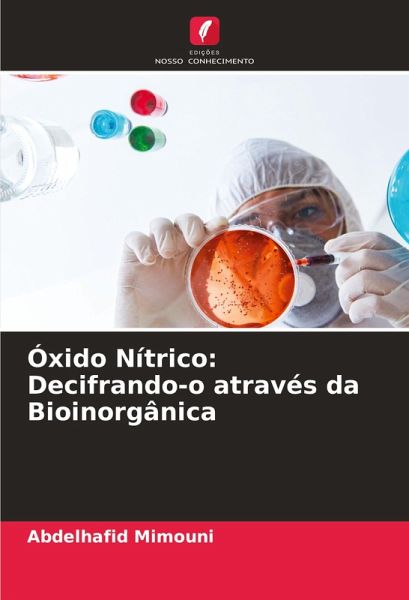
Óxido Nítrico: Decifrando-o através da Bioinorgânica Óxido Nítrico: Decifrando-o através da Bioinorgânica

Óxido Nítrico: Decifrando-o através da Bioinorgânica
Versandkostenfrei!
Versandfertig in 6-10 Tagen
29,99 €
inkl. MwSt.
PAYBACK Punkte
15 °P sammeln!
Nitric Oxide Revealed by Bioinorganics" explora em profundidade o papel vital do óxido nítrico (NO) em vários processos biológicos, com particular ênfase na sua interação com compostos metálicos. O livro examina os mecanismos de produção de NO, as suas propriedades fisiológicas e a sua influência em sistemas-chave, como o sistema cardiovascular e o sistema imunitário. Ao integrar os princípios da bioinorgânica, ilumina as ligações entre os metais e o NO, proporcionando uma compreensão aprofundada da sua importância na biologia. Com uma análise pormenorizada e referências c...
Nitric Oxide Revealed by Bioinorganics" explora em profundidade o papel vital do óxido nítrico (NO) em vários processos biológicos, com particular ênfase na sua interação com compostos metálicos. O livro examina os mecanismos de produção de NO, as suas propriedades fisiológicas e a sua influência em sistemas-chave, como o sistema cardiovascular e o sistema imunitário. Ao integrar os princípios da bioinorgânica, ilumina as ligações entre os metais e o NO, proporcionando uma compreensão aprofundada da sua importância na biologia. Com uma análise pormenorizada e referências científicas sólidas, este livro é um recurso essencial para investigadores, estudantes e profissionais interessados na química bioinorgânica e nas suas implicações biológicas.